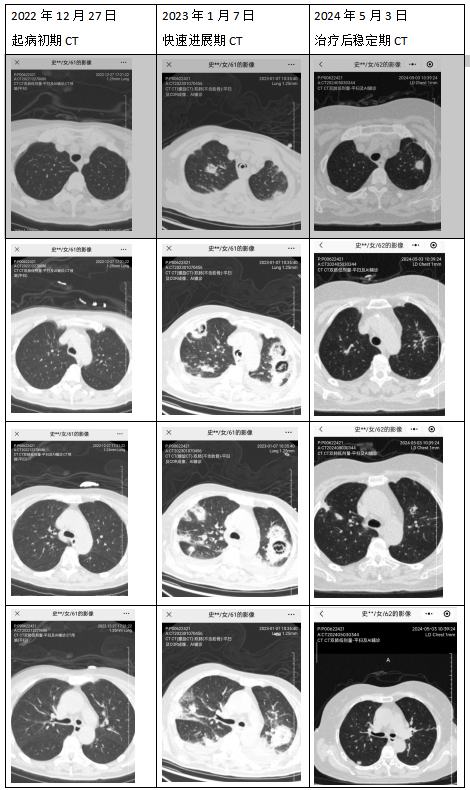

主办单位:中国民族卫生协会基层卫生人才工作委员会   All Rights Reserved 
                技术支持单位:北京天元中和医药科技研究院 
                京ICP备09057878号-6
            
        理论研究
当前位置:首页 > 理论研究 多学科协作下侵袭性肺曲霉菌病合并机化性肺炎的全程管理与医防融合实践
            作者:烟台市烟台山医院      阅读: 40 次      来源:基层卫生人才工作委员会   
            费建文、韩进
烟台市烟台山医院
一、案例背景
	        政策与社会需求 
 
	       随着《“健康中国2030”规划纲要》的深入推进,医防融合成为慢病管理的核心策略。侵袭性真菌感染及机化性肺炎等呼吸系统难治性疾病,病程长、易复发,对患者生活质量与医疗资源均构成重大挑战。本案例立足于提升复杂感染与炎症性肺病的全程管理水平,体现医防结合在重症恢复期与慢性期管理中的实践价值。 
 
	       实施主体简介 
 
	       烟台市烟台山医院作为三级甲等综合医院、国家医防融合试点单位,呼吸科牵头联合重症医学科、内分泌科、影像科、病理科及康复科,构建多学科诊疗(MDT)团队,服务于本地区中老年、合并多种慢病的复杂患者群体。 
 
	       问题与挑战 
 
	      传统诊疗模式中,复杂肺部感染与并发症管理存在诊断滞后、治疗矛盾、随访碎片化、患者依从性差等问题,尤其在合并糖尿病、多脏器功能不全等基础疾病的情况下,管理难度进一步加大。 
 
	       二、案例设计与实施 
 
	      目标定位 
 
	      短期目标:控制感染,纠正代谢紊乱,稳定生命体征。 
 
	      长期愿景:实现疾病持续缓解,提升患者生活质量,建立可推广的复杂肺病随访管理体系。 
 
	      融合机制 
 
	      组织架构:建立“重症-专科-社区”三级联动机制,实现从急危重症救治到稳定期社区随访的无缝衔接。 
 
	       服务流程: 
 
	       急性期:快速诊断→强化抗感染→生命支持; 
 
	       恢复期:影像评估→病理确诊→个体化用药; 
 
	       慢性期:定期复诊→远程随访→康复指导。 
 
	        技术支撑: 
 
	       依托医院信息化平台,实现影像、病原学、病理数据共享,辅助临床决策。 
 
	       特色创新 
 
	       多学科整合诊疗:呼吸、重症、内分泌、康复等多科协作,制定一体化治疗方案。 
 
	全程化随访体系:通过“门诊+电话+微信”多元随访,强化患者教育与用药指导。 
 
	病理引导的精准治疗:在影像学进展时及时行肺穿刺活检,明确机化性肺炎诊断,避免误治。 
 
	       三、实施成效 
 
	       量化指标: 
 
	       患者随访率达100%,复诊依从性超过90%。 
 
	       肺部病灶控制率显著提升,空洞病灶基本吸收。 
 
	       血糖控制达标率持续维持在理想范围。 
 
	       实质性成果 
 
	       患者从卧床、呼吸机依赖恢复至生活自理,生活质量显著改善。 
 
	       医护团队在复杂肺病诊治与慢病管理方面的综合能力得到提升。 
 
	       本案例作为典型复杂病例在医院内及省内进行多次交流分享。 
 
	       典型案例 
 
	       患者史某某,61岁,女性,因糖尿病酮症酸中毒继发侵袭性肺曲霉菌病、机化性肺炎,历经三次住院,通过抗真菌、激素调节、支气管镜介入及康复治疗,目前病情稳定,恢复良好,定期随访中,体现了医防融合在复杂慢病管理中的成功实践。 
 
	       病例基本信息 
 
	       患者史某某,女,61岁,汉族,农民,已婚,出生地山东烟台栖霞。 
 
	       主要诊断: 
 
	1. 侵袭性肺曲霉菌病   
 
	    呼吸衰竭 
 
	2. 机化性肺炎 
 
	3. 2型糖尿病酮症酸中毒  
 
	4. 新型冠状病毒感染 
 
	5. 休克 
 
	6. 气管内占位 
 
	7. 心功能不全 
 
	8. 肾功能异常 
 
	9. 下肢深静脉血栓 
 
	       病例摘要 
 
	       患者于2022年12月27日因“咳嗽2天,恶心、呕吐伴意识不清1天”入院。急诊检查提示多项指标严重异常,其中pH 6.87,血糖 47.64mmol/L,血钾 6.66mmol/L,白细胞 32.73×109/L,急诊以酮症酸中毒收住急诊重症监护病房。入院后经积极救治,血糖得到控制,酸碱及电解质失衡得以纠正。12月31日出现呼吸衰竭加重、休克,给予气管插管、呼吸机辅助呼吸、血管活性药物治疗。1月7日复查肺CT示双肺新出现多发空洞样病灶,提示侵袭性肺曲霉菌感染。经伏立康唑、两性霉素B等抗感染和综合治疗后病情逐渐好转;针对下肢深静脉血栓给予抗凝治疗;针对脏器功能异常给予对症治疗;针对长期卧床、活动能力差给予康复治疗;经治疗后患者病情平稳并出院。定期复查,曲霉病灶逐渐缩小。2023年7月因症状加重、病灶较前增大再次住院。行超声引导下经皮肺穿刺检查病理诊断为机化性肺炎。加用激素等药物治疗;针对气管内占位进行电子支气管镜下圈套切除。院外定期对患者进行随访管理,患者恢复了生活自理能力,肺部病灶逐渐吸收减少并稳定,但随着药物的减量,病灶时有反复,故不断调整药物,保持维持病灶稳定的最小剂量药物。目前已随访2年余,病情稳定。 
 
	        四、经验总结与推广 
 
	        成功要素 
 
	        以患者为中心的多学科协作(MDT)诊疗模式 
 
	       本案例的成功,首要归功于贯穿始终的多学科协作机制。在急性期,重症医学科主导的生命支持为后续治疗赢得了宝贵时间;呼吸科精准把控抗感染与抗炎治疗的平衡点;内分泌科全程介入血糖管理,为感染控制奠定了坚实基础;影像科与病理科的密切配合,实现了从影像学疑点到病理学确诊的关键飞跃;康复的早期介入则有效改善了患者的功能状态与预后。这种打破学科壁垒的协作模式,确保了诊疗决策的全面性与科学性,避免了单科诊疗的局限性。 
 
	       诊断过程中对病理学证据的执着追求与关键应用 
 
	       在患者病情出现反复、影像学表现不典型时,治疗团队没有停留在经验性治疗的层面,而是果断决策,通过“超声引导下经皮肺穿刺”获取病理组织。这一关键举措,明确了“机化性肺炎”这一与曲霉菌病治疗策略相矛盾的新诊断,从而及时调整治疗方案,加用糖皮质激素,避免了因误判为真菌感染复发而盲目强化抗真菌治疗可能带来的风险。这体现了“精准医疗”的核心思想,即依靠客观证据指引临床决策。 
 
	      贯穿急性期与稳定期的全程化、主动式随访体系 
 
	      本案例超越了“一次性住院治愈”的传统模式,构建了长达两年多的系统随访管理路径。该体系融合了门诊复诊、电话及微信随访等多种形式,不仅监测影像学变化和生化指标,更密切关注患者的症状、心理状态、用药依从性与生活质量。这种主动、连续的随访,实现了对病情变化的早期发现、早期干预(如激素剂量的及时调整),并通-过持续的医患沟通,建立了牢固的信任关系,是保障长期治疗成效的“稳定器”。 
 
	       医患同盟与高效沟通构建的治疗依从性 
 
	       面对复杂漫长的病程和潜在的治疗矛盾,医护人员高度重视沟通的艺术。治疗前充分告知,治疗中耐心解释,稳定期持续鼓励,使患者及家属从被动的接受者转变为主动的参与者。患者对医疗方案的深刻理解和高度信任,是其能够坚持长达两年的伏立康唑治疗并规律复诊的根本前提。这种基于共情与互信的医患关系,是所有技术手段得以有效实施的软性基础。 
 
	       局限性 
 
	       医疗资源的高度集中性与基层推广的挑战 
 
	       本案例的成功严重依赖于三级甲等医院强大的多学科平台、先进的介入操作技术(如支气管镜下圈套切除、肺穿刺)和昂贵的抗真菌药物。在医疗资源相对薄弱的基层医疗机构,缺乏相应的设备、药品和专家团队,难以独立完成此类复杂疾病的诊疗全流程。这揭示了优质医疗资源下沉不足的现实问题,限制了该管理模式在更广阔范围内的直接复制。 
 
	       长期治疗带来的显著经济负担与药物副作用管理压力 
 
	       伏立康唑等抗真菌药物费用高昂,长期服用对患者家庭构成了沉重的经济负担。同时,伏立康唑本身存在肝毒性、视觉障碍等潜在副作用,与糖皮质激素联合应用时,进一步增加了血糖控制难度以及感染、骨质疏松等风险。管理这些复杂的药物相互作用与不良反应,需要患者具备较高的自我管理能力,并对医疗团队的监测和调整提出了更高要求。 
 
	       疾病本身的复杂性带来的治疗矛盾与决策困境 
 
	       侵袭性肺曲霉菌病需要强化抗真菌免疫,而机化性肺炎则需要使用激素抑制免疫反应,两者在治疗上存在根本性的矛盾。如何把握抗真菌与抗炎治疗的“平衡点”,没有现成的标准答案,完全依赖于MDT团队的经验判断和动态评估。这种决策的高度不确定性,是本案管理中最核心的难点与局限,也存在因判断失误导致病情反复的风险。 
 
	       信息化支持的“数据孤岛”问题 
 
	       尽管院内信息化平台提供了支持,但医院与社区医疗机构之间的健康档案系统尚未完全打通,患者的社区随访数据、自我监测数据未能完全整合入医院的主病历系统。这在一定程度上影响了随访信息的完整性与连续性,是实现真正全域、全周期健康管理的瓶颈所在。 
 
	       推广建议 
 
	       本案例所探索的复杂肺病全程管理模式的推广,应遵循“分层次、建路径、强支撑、促联动”的原则,将其核心理念与具体做法适配于不同医疗场景。 
 
	       构建分级协作的医防融合网络 
 
	       核心层(三级医院):定位为“疑难诊疗中心与技术支撑平台”,负责复杂病例的精准诊断、急性期救治、方案制定,并向下级机构提供技术指导、远程会诊和人员培训。 
 
	      枢纽层(二级医院/区域医疗中心):定位为“稳定期管理枢纽”,负责执行三级医院制定的治疗方案,处理常见的病情波动,并向上转诊危重患者,向下指导基层机构。 
 
	网底层(社区卫生服务中心/乡镇卫生院):定位为“健康守门与随访哨点”,负责患者的日常症状监测、用药督导、生活方式干预、定期复查提醒,以及及时发现异常并向枢纽层反馈。 
 
	       推广路径:鼓励组建以三级医院呼吸科为核心的“区域呼吸疾病医联体”,通过签订合作协议、建立转诊绿色通道、共享电子病历关键信息,实现“基层首诊、双向转诊、上下联动”的闭环管理。 
 
	       制定标准化的关键环节操作路径(SOP) 
 
	       推广路径:将本案例中的成功实践提炼成标准化操作文件,例如:侵袭性肺真菌感染与机化性肺炎的鉴别诊断与病理检查指征SOP、肺曲霉菌病合并机化性肺炎的药物治疗平衡策略、慢性呼吸系统疾病患者院外随访管理手册(包含症状日记、用药记录、紧急情况处理指引等。这些标准化工具能有效降低诊疗过程的随意性,提升基层医疗机构的处置能力。 
 
	       依托信息化平台实现连续性的健康管理 
 
	      推广路径:建议在现有医院信息管理系统(HIS)基础上,拓展或对接“慢病管理平台”功能。该平台应实现: 
 
	      随访计划自动生成:根据诊断和出院医嘱,自动为患者生成个性化的复查、随访时间表。 
 
	      患者端数据接入:支持患者通过手机APP上报症状、上传居家监测指标(如血糖、血氧饱和度)。 
 
	      预警与提醒:系统对异常上报数据或逾期未复查的患者自动预警,提醒医护人员主动介入。 
 
	      通过技术手段,将间歇性的、被动的医疗服务,转变为连续的、主动的健康管理。 
 
	      加强面向基层的人才培养与同质化培训 
 
	      推广路径:由三级医院定期组织“复杂肺病全程管理”培训班、线上研讨会,并接受基层医护人员进修。培训内容应侧重于: 
 
	      早期识别:如何从常见呼吸道症状中筛查出潜在的重症真菌感染或机化性肺炎线索。 
 
	      规范转诊:明确转诊标准和流程,确保患者在关键时刻能获得上级支持。 
 
	      社区康复:学习呼吸康复的基本技能,指导稳定期患者改善肺功能。 
 
	      目标是提升整个区域医疗网络对复杂呼吸疾病的同质化诊疗管理水平。 
 
	      探索基于价值的医保支付方式改革 
 
	      推广路径:积极向医保部门建言,探索适用于此类慢病全程管理的“按价值付费”或“按人头打包付费”模式。将急性期后的随访管理、康复指导、患者教育等费用纳入支付范围,从经济机制上激励医疗机构主动开展医防融合服务,确保管理模式的可持续性。 
 
	      通过以上多维度的推广策略,本案例中验证有效的管理理念与方法,将能够以一种系统化、可复制的方式,惠及更广泛的医疗机构与患者群体,真正推动呼吸系统慢病管理质量的整体提升。 
 
	       五、支撑材料 
 
	       参考文献 
 
	     《中国肺真菌病诊疗指南》 
 
	       美国感染病学会《曲霉病诊治指南》2016 
 
	      《健康中国2030规划纲要》 
 
	附录 
 
图1:各时期影像学变化对比图
    
 
	
